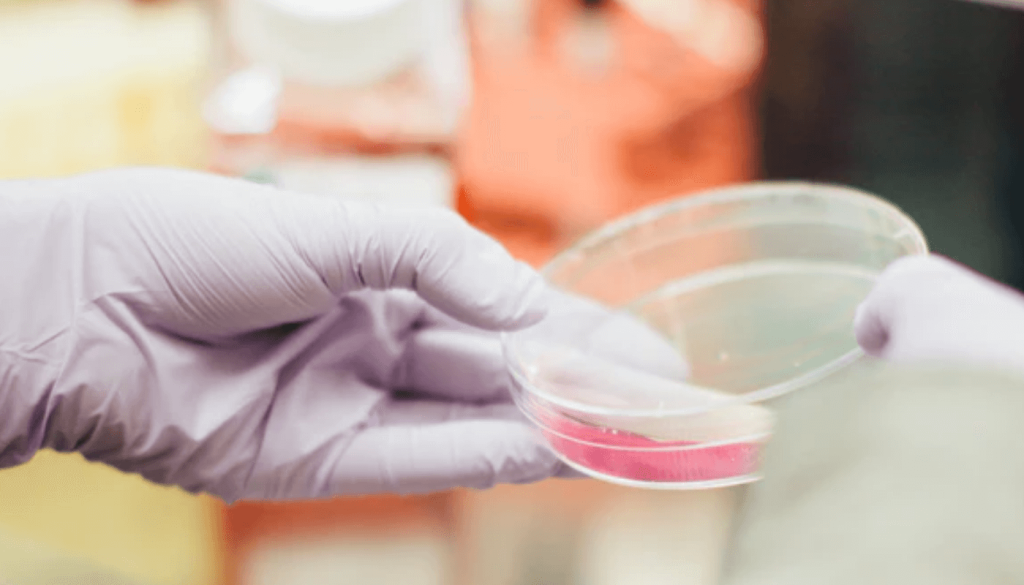

Fat is back in vogue: younger consumers want more fatty products according to studies

It seems that younger consumers are losing their fear of fat – according to the latest studies. One of those; a five-year study from New Nutrition Business (NNB) quoted that the younger generation are now more open to the idea that fat isnt all that bad after all with 34% of consumers aged 35 to […]
Womens Entrepreneurship Day: the female founded startups leaving their mark on foodtech

Last November 19th was an important day for us at Food Entrepreneurs as we celebrated Womens Entrepreneurship day, a special day to honor the strong and empowering female founders, entrepreneurs, makers, creators and doers who continue to inspire us across the food industry, and we wanted to give the female foodies making their mark on […]
An interview with Orbillion Bio: Bringing clean meat to the modern consumer

Orbillion Bio is on a mission to bring healthy, sustainable and flavorful meats with a complete farm-to-table story to the modern consumer. The innovative startup is looking to develop premium cell-based meat products from heritage cell lines that are directly sourced from farmers, all to accelerate the broad availability of nutritious cultivated meat products. The […]
An interview with Orbillion Bio: bringing clean meat to the modern consumer
Orbillion Bio is on a mission to bring healthy, sustainable and flavorful meats with a complete farm-to-table story to the modern consumer. The innovative startup is looking to develop premium cell-based meat products from heritage cell lines that are directly sourced from farmers, all to accelerate the broad availability of nutritious cultivated meat products. The […]
5 foodtech trends driving consumers towards connected kitchens

Nowadays, the kitchen is no longer just a workspace but is developing more and more into the primary center of life for users and thus the center of the (smart) home. In our latest post we decided to take a look at the foodtech startups leading the new household revolution: the connected kitchen. Smart fridges […]
World vegan month: why the future of food is still plant-based

With a spike in plant-based brands across the foodtech spectrum and increasingly more consumers switching to vegan lifestyles, in our latest post we look at what is driving this change and the exciting opportunity it offers to investors, retailers, startups and other players in the food industry. Green is going mainstream. The plant-based sector is […]